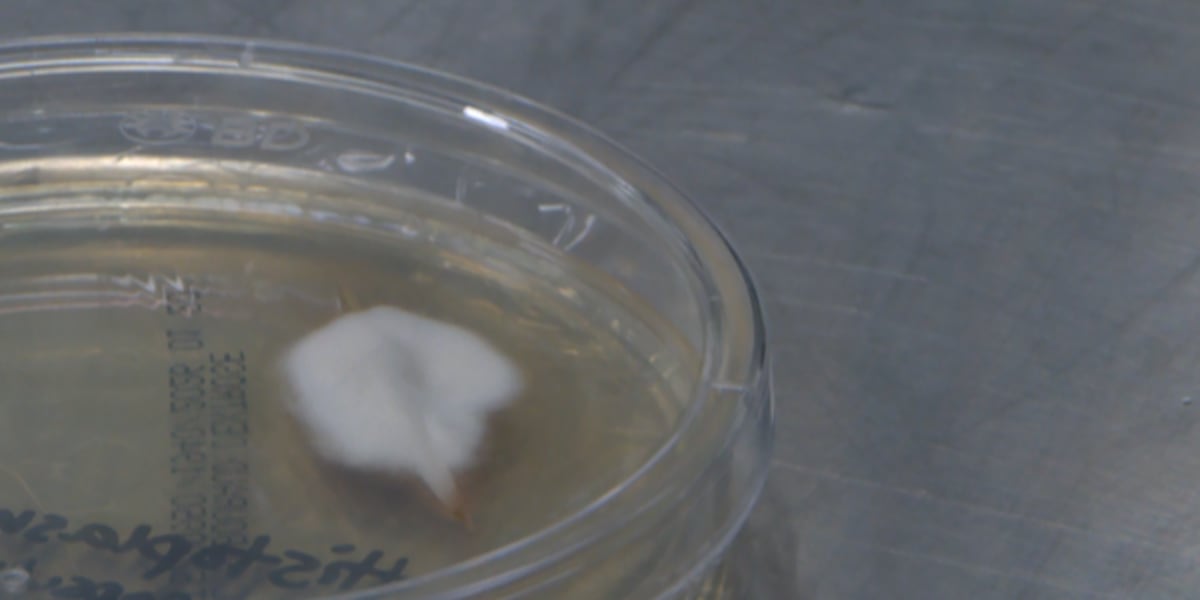
Nashville boy living with rare complication from histoplasmosis, fungal infection rising in Middle Tennessee

NASHVILLE, Tenn. (WSMV) - The Tennessee Department of Health is warning about a rise in cases involving a fungus.
They now say they’ve seen more than 20 cases of histoplasmosis, a fungal infection caused by breathing in spores typically found in soil containing bird or bat droppings.
Previous Coverage: Midstate seeing rise in histoplasmosis, fungus infection spread by breathing in spores
The infection affected one Nashville family when Graham Daniel, who was 8 years old at the time, developed what initially appeared to be cold symptoms and fever.
But the condition became concerning when his symptoms didn’t improve for weeks. In April 2023, doctors discovered fluid around his heart, leading to an eight-day hospital stay.
“I had never even heard of histoplasmosis at the time,” said L

 WSMV 4 Nashville
WSMV 4 Nashville
Raw Story
Raw Story America News
America News AlterNet
AlterNet Joplin Globe Sports
Joplin Globe Sports 6abc Action News Sports
6abc Action News Sports Post Register
Post Register